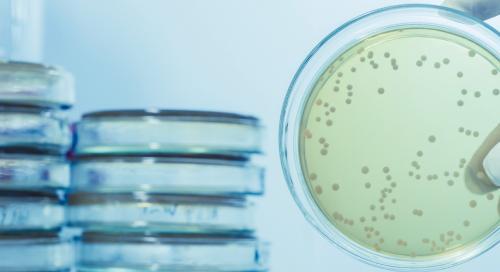
Photograph of Microbiological Testing

Home - Our Services
Our Services

Asbestos
Explore our specialist asbestos services, supporting safe, compliant management from initial survey to removal.
Chemical Testing
Explore our expert chemical testing services, providing precise analysis to ensure safety and compliance.
Microbiological Testing
Discover our microbiological testing services, ensuring water quality and safety by detecting harmful pathogens such as Legionella.


